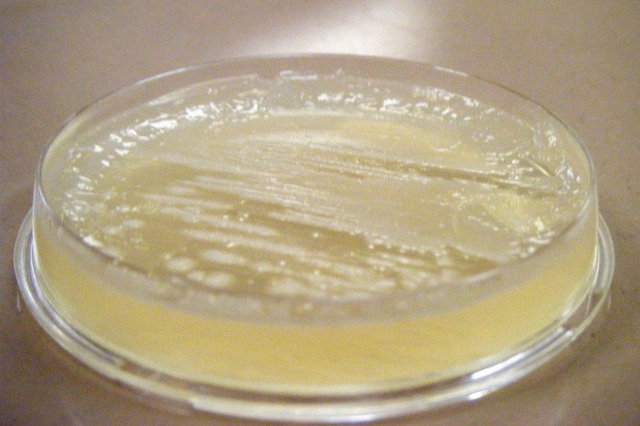
Day 3

-
Temp: 8.0c
Phydrion: 7
Looks: normal -
Temp: 23.6c
Phydrion: 7
Looks: Normal -
Temp: 22.6c
Phydrion: 6
Looks: Thicker -
Made Petri Dish
-
Temp: 22.1c
Phydion: 6
Looks: Solid/Chucky -
We put milk on a slide with crystal purple stain. Let it sit for two minutes. Than examined the milk under microscope.
Plan projects on a visual timeline
Map milestones, phases, deadlines, and key events in one place so the sequence is easier to see and share. Timetoast is a timeline maker for work, school, research, and stories.